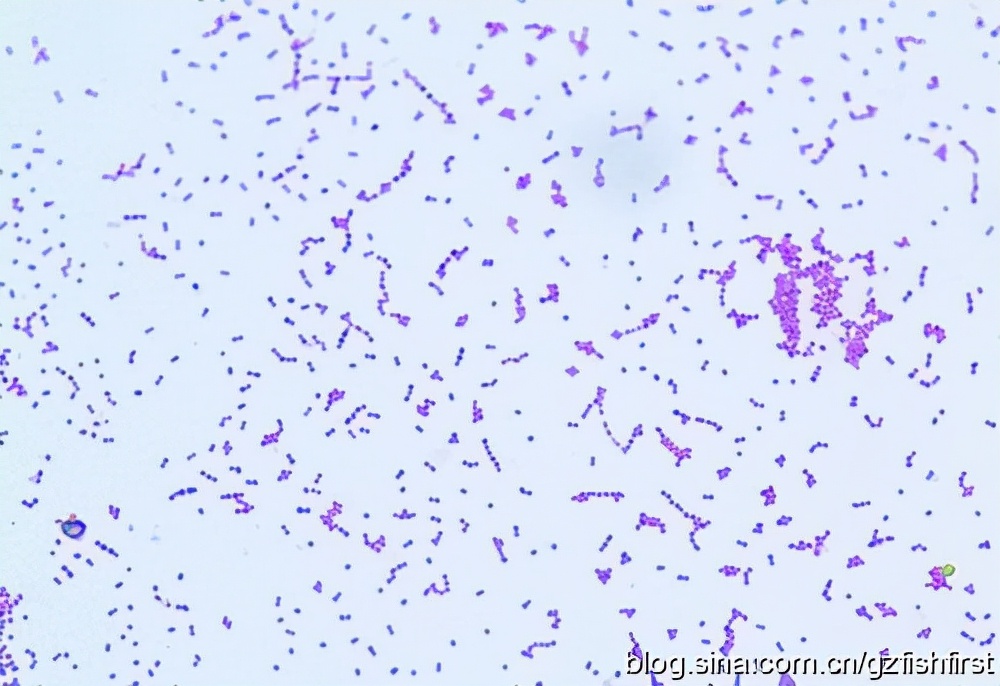
罗非鱼细菌病害防治,罗非鱼得链球菌病的对比图

深 知养殖从业不易,共谋水产行业繁荣。不误导不夸大不炒作不标题*党**。用养殖人的语境,让你在短时间内享用一份精品!

本文就罗非鱼无乳链球菌病的流行情况、临床症状、致病机理、诊断方法和防治措施作一简介,为广大基层水产工作者和养殖户对罗非鱼无乳链球菌病的防控提供借鉴。自2009年以来,我国南方多个省市暴发了罗非鱼链球菌病,其发病率高达40%,死亡率接近100%;链球菌一度被人喻为罗非鱼世界的“H1N1”。在不少养殖地区经常可见由于疾病暴发而倾家荡产的养殖户,疾病的发生严重挫伤了养殖户养殖积极性,也给当地罗非鱼饲料销售商、出口商以及渔政部门等相关利益方带来极大的困扰;病害也给当地罗非鱼产业造成巨大的经济损失。广大罗非鱼养殖户与行业行政主管部门都急切呼吁尽快搞清罗非鱼链球菌病的病原学特性及其致病机理,同时建立特异性强、灵敏度高的诊断方法,筛选有效的防治药物,研制安全、高效的新型疫苗等,以降低疾病对罗非鱼养殖的危害,促进罗非鱼养殖的健康发展。本文就罗非鱼无乳链球菌病的流行情况、临床症状、致病机理、诊断方法和防治措施作一简介,为广大基层水产工作者和养殖户对罗非鱼无乳链球菌病的防控提供借鉴。

一、病原学特征 无乳链球菌(Streptococcus agalactiae)亦称GBS(group B Streptococcus),属于链球菌科(Streptococcace)链球菌属(Streptococcus),为B群链球菌,革兰氏阳性,呈链状或成对排列的球菌。其在自然界中分布广泛,普遍存在于水,动物体表,泌尿生殖道和乳汁中,对哺乳动物、爬行动物、两栖动物和鱼类均有致病性,是一种人-兽-鱼共患病病原。无乳链球菌可引起新生儿的败血症、肺炎和脑膜炎,奶牛乳腺炎和鱼的脑膜炎,给人类的健康带来威胁,也给家畜和水产养殖业造成严重的经济损失。无乳链球菌菌体为圆形或卵圆形,直径约为2μm,链状或成对排列,在肉汤内对数生长期,常呈成长链排列,无鞭毛,无芽孢,无运动性。无乳链球菌为兼性厌氧菌,过氧化氢酶阴性。在血液琼脂平板上培养18h-24h后,形成淡灰白色、隆起、闪光的小菌落。大多数无乳链球菌菌株在10℃或45℃或pH9.6的条件下不生长,最适温度为36℃-37℃,最适pH为7.4-7.6。在普通培养基中生长不良,在血液琼脂培养基,脑心浸液培养基等营养成分较高的培养基中生长良好,能在含40%胆汁的培养基中生长,不能在6.5%NaCl中生长。大部分无乳链球菌菌株呈β-溶血,但也有α-或γ-溶血。能水解马尿酸钠,精氨酸,不水解七叶苷,能发酵葡萄糖、麦芽糖、蔗糖、海藻糖产酸不产气,只在好氧条件下发酵甘油,不发酵木糖、阿拉伯糖、棉子糖、菊糖、甘露醇和山梨醇。根据细菌表面荚膜多糖抗原不同将无乳链球菌分为Ⅰa、Ⅰb、Ⅱ-Ⅸ 10种血清型。其中血清型Ⅰa、Ⅲ、Ⅴ已被报道是引起人类疾病的主要血清型,血清型Ⅰa、Ⅰb和Ⅲ型是感染鱼类的主要血清型。

图1 罗非鱼无乳链球菌病表现为(左)角膜发白浑浊,(右)眼球肿大突出
二、疾病流行情况 近几年来,全球范围内无乳链球菌感染多种海水和淡水养殖鱼类并引起暴发性疾病的报道呈现增加趋势,尤其在亚洲的罗非鱼养殖地区报道较多,无乳链球菌已给亚洲的罗非鱼养殖业造成了严重的危害。中国、泰国、马来西亚、科威特等国均暴发了严重的罗非鱼无乳链球菌病,有较高的发病率和死亡率。本病在我国南方地区5-10月的高温期容易流行,流行水温25-37℃,发病率达20%-30%,发病鱼的死亡率可高达60%-100%;水温降至20℃以下时则发病较少;在高水温季节时,病鱼的死亡高峰期可持续2-3周,在低水温季节,病鱼呈慢性发病,死亡率降低,但持续时间长。疾病主要威胁100g以上的稚鱼到1kg左右的成鱼;无乳链球菌病主要以水平方式传播,体表有损伤或受环境应激过大的鱼易感染发病。暴发无乳链球菌病的罗非鱼往往伴有其他细菌病如爱德华氏菌、弧菌、嗜水气单胞菌等的混合感染,加剧罗非鱼的死亡。

图2 双侧眼球肿大突出
三、疾病临床症状 感染无乳链球菌的罗非鱼表现为全身性的充血、出血伴有严重的炎性反应。病鱼表现为食欲减退,游动不稳定呈螺旋状,水面惊吓无反应呈昏睡状,有的停滞在水面,有的身体弯曲。病程较长的罗非鱼表现为角膜发白浑浊、眼球肿大突出,虹膜充血,严重的可见眼球脱落,由于罗非鱼感染无乳链球菌时眼球肿大突出的现象多见,具有一定的示病性,因此养殖户多称此病为“突眼”症。

图3 眼球肿大突出,虹膜充血
下颌、鳃盖边缘、鳍条基部不同程度的充血、出血;慢性感染往往出现体表脓肿,尤其是在下颌骨或鳍条基部的位置可见2-3毫米大小的脓肿,尾部可见10-20厘米的大脓肿。急性感染伴有腹水、肛门红肿、外突的现象。解剖可见胃肠道内空无食物,肝脏肿大充血,颜色不均,质地脆弱,胆囊充盈、充满蓝黑色的胆汁。脑膜充血明显,肠道有轻度的充血和炎症,肠腔内有少量黄色的粘液。
图4 革兰氏染色分离菌株球菌
进一步的组织病理学观察显示发病罗非鱼肝脏肝细胞呈颗粒变性、肿胀,局部灶性坏死,坏死灶内肝细胞核浓缩、细胞核破裂,甚至有一定区域呈现细胞崩解形成均质红染的无结构物质,并有多量炎症细胞浸润。脑严重水肿,脑基质出现大量间隙,呈海绵状,神经细胞肿胀、变性,神经胶质细胞增多,血管周围间隙明显增宽。肠腔中充斥大量的脱落的上皮细胞、炎性白细胞和均质红染蛋白性渗出物,固有膜血管充血,有大量炎症细胞浸润。眼底部淤血严重,水肿,细胞间隙明显增宽,大量巨噬细胞和嗜中性粒细胞浸润,部分细胞坏死,其胞核固缩或碎裂。

图5 电镜下的无乳链球菌 四、致病机理 罗非鱼是无乳链球菌高度敏感的宿主。病原菌如何通过黏膜和组织屏障而侵入血液循环,早期研究提示单核细胞携带细菌或通过其他机制进行散播,如细胞噬菌作用。此外,荚膜多糖(CPS)在链球菌中具有抗吞噬作用,因此,细胞外链球菌能在血液中自由传播。同时,链球菌对吞噬细胞有一种相对较高的粘附作用,而不是被吞噬,细菌能大量地粘附在巨噬细胞上不被其消化,这可能是持续的菌血症和散布菌源的原因。链球菌对脑微脉管内皮细胞(BMEC)的粘附作用以及细菌分泌出毒性因子作用于内皮细胞可能对链球菌能穿越血脑屏障(BBB)有重要有作用。Klesius和Evans等人研究了无乳链球菌胞外产物(ECP)对尼罗罗非鱼巨噬细胞的趋化活性,表明无乳链球菌的胞外产物能够引起巨噬细胞的趋化现象和化学增活现象,并认为进一步研究无乳链球菌胞外产物与巨噬细胞的特异性反应,以及这种反应是如何引起巨噬细胞游走,吞噬和杀菌力作用,将有助于对无乳链球菌发病机理的研究。目前报道最多的无乳链球菌毒力因子主要有荚膜多糖,胞外毒素和CAMP因子等。荚膜多糖作为该菌关键的毒力因子,经唾液酸修饰后可钝化宿主旁路补体激活途径进而产生致病作用。无乳链球菌可以产生外毒素,其中β-溶血素,具有溶血性和动物致死性等,可直接破坏宿主组织的结构和功能,导致靶器官的功能紊乱,加之红细胞被外毒素大量破坏,机体最终衰竭死亡。有报道称CAMP因子是无乳链球菌的主要毒力因子。另外,C蛋白β抗原以及无乳链球菌发酵葡萄糖代谢产生的乳酸也可能是无乳链球菌的毒力因子。 五、诊断方法 鱼类生活在复杂的水环境中,水体中存在大量的条件病原体,疾病的发生早期可能是单因素所致,病程越长继发多种病原感染的可能越大,如感染链球菌的病鱼,由于体质严重下降容易继发气单胞菌等条件致病菌感染;而寄生虫病导致的体表破溃性创伤,又容易继发细菌病和真菌病的发生;因此在疾病诊断时要考虑多病原联合感染的可能,综合的考虑多种因素(包括饲料变质、养殖密度过大等非生物因素)才能做到疾病的快速准确诊断。此外,鱼病的发生发展是个复杂的过程,存在“多因一症”的现象,如彩虹病毒病、链球菌、假单胞菌和爱德华氏菌等多个细菌性疾病都可能观察到罗非鱼眼球的充血、白浊和凸出的现象;长期使用同一种饲料导致鱼体营养不全或某种营养素缺乏,病鱼也可以观察到“突眼”症。因此,对于罗非鱼无乳链球菌病的快速准确诊断还得需要借助微生物学方法、血清学方法或分子生物学方法。近年来,农业部在水产养殖的重点县市构建了水生动物病害诊断实验室,为基层病害的快速诊断提供条件,基层养殖户在进行疾病的诊断时,可求助于当地的渔政机构或科研院所。对于罗非鱼无乳链球菌病的确诊可以结合临床症状、病原检测和分子快诊技术:1、观察发病鱼是否具有如嗜睡打转、眼球突出或浑浊发白、脑膜炎、内脏器官及体表出血等典型病理变化;2、采集发病鱼的组织,制备组织触片进行吉姆萨染色,借助光学显微镜油镜观察是否存在成双或成链状的球性细菌;3、在无菌条件下,从发病鱼的组织中是否分离到致病性链球菌,有条件的可采用生化方法、免疫学方法或分子生物学方法对分离细菌进行准确鉴定来确诊。目前链球菌的商用鉴定系统有RAPID Strep Strip,Viteck system,API 20 STREP和ATB Expression,这些商用鉴定系统使用方便,准确可靠。本实验室以无乳链球菌的具有高度保守性的荚膜多糖基因和CAMP因子基因为检测序列,成功建立了快速检测罗非鱼无乳链球菌的PCR方法,这个方法具有简便、快速、灵敏、准确和特异性等优点。 六、防治措施 对于罗非鱼无乳链球菌病的防治强调“防重于治”,可以从改善和优化养殖环境、提高饲料质量、增强鱼体自身抵抗力、切断病源传播途径和科学使用疫苗等方面进行罗非鱼疾病的综合防治,除了做好平时的养殖管理外,最好把使用疫苗作为本病预防的重要方法,甚至可提高到首选方法的地位。在药物防治方面,尤其是平时预防时,我们建议以下用药原则:能不用药则不用,必须用则少用;尽量使用中草药而不是用化学药物,一旦使用化学药物,必须使用制剂,不使用原药,严格遵守休药期。与此同时,需要提醒各养殖户的是,许多鱼类的病原体也是可以感染人类的,如无乳链球菌都能引起人类的组织感染,尤其是手上有伤口且体质较弱的人员较易感染。 改善水体水质 水环境是鱼类赖以生存的必要条件,水质的好坏直接决定着罗非鱼能否健康、快速的生长。盲目扩大鱼类的养殖密度、强化投饵量都会加重水体的负担,破坏原有的生态平衡。研究证实高密度放养情况下会增加疾病的发生概率,这是由于密度过大鱼类的抗应激能力下降,加之鱼类代谢产物增多若换水不足,水中溶氧过低易引起水质恶化,使池中亚硝酸盐浓度上升,乃至中毒,并导致鱼体抵抗力下降,从而导致细菌继发性感染如链球菌和嗜水气单胞菌的感染。因此养殖密度不宜过大。此外,通过改变生态系统的构成来控制某些细菌的过度繁殖,或者使用合理剂量的消毒剂来抑制病原菌的增生是可行的,当然如果在高温季节能有办法降低养殖水温也是非常关键的防病措施,可惜到现在为止我们还没有办法做到。 免疫增强剂 不少研究表明在鱼饵料中添加一些免疫增强剂可以明显提高罗非鱼的免疫力和抗病能力,如全雄奥尼罗非鱼饲料中?-葡聚糖添加量在1.0%-1.5%时,可以明显改善其生长性能和抗嗜水气单胞菌感染的能力;黄芪多糖能够增加罗非鱼的免疫功能,有抗菌、抗病毒,解毒,抗炎,抗应激等功能;松籽多糖对奥尼罗非鱼有免疫调节作用和较强的抗氧化作用;云芝多糖能够提高奥尼罗非鱼经嗜水气单胞菌攻毒后的存活率。此外,酵母多糖、维生素C和维生素E等均有提高鱼体免疫力的作用,复合微生态制剂加入奥尼罗非鱼的基础饲料中也被证实能提高奥尼罗非鱼的抗病力。因此,在鱼类饵料中适当加入免疫增强剂可以有效提高鱼体抗病能力。 疫苗 免疫接种是一种相对健康安全的疾病预防措施,虽然鱼类的特异性免疫机制还很不完善,但国内外研究已证实鱼类免疫疫苗对鱼体能够产生免疫保护力。目前罗非鱼上研究最多的是链球菌疫苗。国外从上世纪九十年代中期便开始进行鱼链球菌疫苗的研究:以色列在1995-1997年间研制的海豚链球菌灭活疫苗使虹鳟的链球菌病死亡率从50%下降到5%。美国也于1999年开始着手研制海豚链球菌灭活疫苗,并在罗非鱼免疫保护实验中,产生较好的保护效果,相对保护率高达93.2%。2009年以来本实验室与通威股份有限公司合作在罗非鱼无乳链球菌的疫苗研究上开展一些工作并取得了一定成绩,研制的注射和口服免疫疫苗实验室免疫保护率分别可达80%和60%。在各方面的不断努力下,国内商品化渔用疫苗的出现指日可待。 中草药治疗 中草药作为天然药物,凭借其无公害、无耐药性、作用广泛等特点受到人们的青睐。中草药在防治鱼类寄生虫病、细菌病和病毒病上发挥着积极的作用。但是由于中草药中有效成分含量较低且用药量大,制剂成本较高,相关的水生动物药效和药动研究基础匮乏等原因,使得中草药在生产上的应用受限。Pongsak和Parichat研究了大蒜、穿心莲、对叶豆、山竺、番石榴和鹊肾树六种草药对尼罗罗非鱼无乳链球菌感染的抗菌作用,发现这六种草药对无乳链球菌均有不同程度的抗菌作用。 化学药物治疗 化学药物治疗疾病是最直接和简便的措施手段,但长期使用或使用不当就难免使病原体产生耐药性导致防治失败,不仅破坏了养殖微生态环境,而且存在的药物残留也会危及人类健康。对于有条件的养殖场,可以通过了解并掌握养殖场内病原菌耐药状况的变化,来筛选有效地疾病预防和治疗用药物。在药物的使用剂量上,并非“猛药能治病”,超剂量的使用药物不仅不能有效地控制疾病,而且药物无论对养殖水体还是对动物的危害都是很大的。因此,严格按照水产用兽药说明书上规定的剂量使用,是获得良好疗效的前提。本实验室对2009年海南多地罗非鱼源无乳链球菌进行了药敏检测结果显示,消毒药中戊二醛、戊二醛癸甲溴铵合剂、聚维酮碘的效果较好;以K-B琼脂扩散法对各分离株进行药敏测试,结果显示不同来源的菌株药敏结果差异大,检测的16种药物中,仅第二代头孢类药物美福仙对各菌株具有敏感杀菌作用,其次是强力霉素和四环素,其它药物对各分离株呈现不同的敏感度,药物防治存在难度,各分离株药敏结果见表1。因而建议用药:1、盐酸强力霉素,每天每千克鱼用药20-50mg,制成药饵,连续投喂5-7d;2、四环素,每天每千克鱼用药75-100mg,制成药饵,连续投喂10-14d;3、有条件的养殖场,可以进行药敏试验结果筛选用药。
(文/图 四川农业大学鱼病研究中心 汪开毓 陈德芳 黄凌远) 作者介绍:汪开毓
四川农业大学动物医学院院长,博士生导师。四川省学术与技术带头人,四川省有突出贡献的优秀专家。中国兽药典委员会委员,农业部新兽药评审委员会委员,中国动物病理学会常务理事,国家重要核心期刊《水产学报》编委会委员,四川省鱼病研究会主任,四川省动物防疫协会副会长。 主编、副主编和参编《现代禽病诊断与防治全书》、《鱼病防治手册》、《鱼病防治与安全用药》、《养鱼全书》、《水生动物病害学(全国统编教材)》、《新编渔药手册》、《动物病理学》、《兽医诊疗新技术》、《水产养殖用药处方大全》、《鱼类疾病彩色诊疗图谱》和《斑点叉尾鮰疾病彩色诊疗图谱》等专著和教材11部。

水产实践人士,共谋渔业繁荣!敬请关注我的头条号@渔人刘文俊,更多精彩内容请登录西南渔业网和养鱼第一线公众号,本文如需转载请注明出处,如有不同见解或者内容补充请私信或留言或评论分享!#链球菌##热带鱼##鱼病#